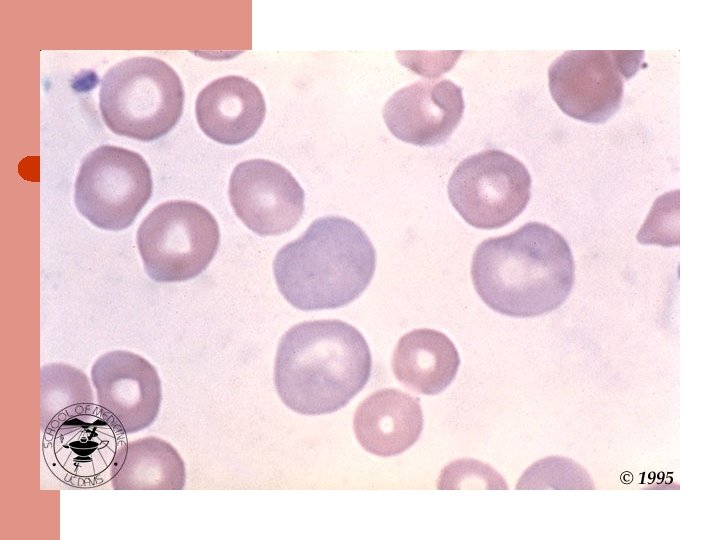
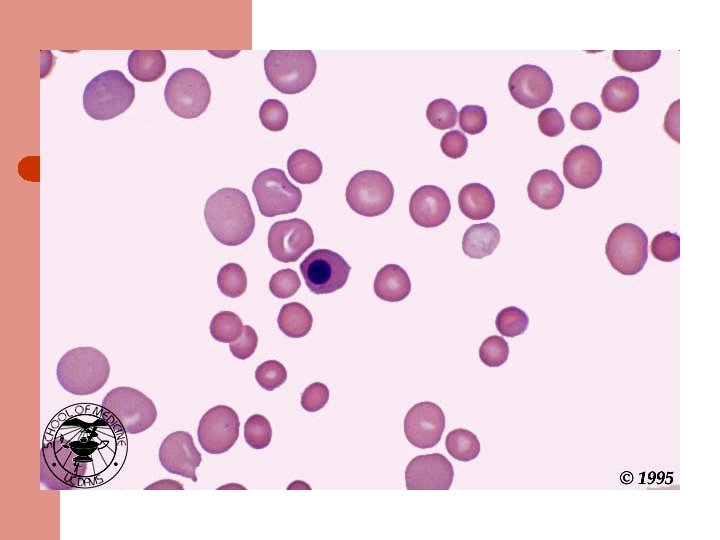

Life of a Red Blood Cell l l

Life of a Red Blood Cell l l Erythroid precursors undergo 4 -5 divisions in marrow, extrude nucleus, become reticulocytes, enter peripheral blood, and survive ~100 -120 days Must withstand severe mechanical & metabolic stress, deform to pass thru capillaries half their size, resist shearing force across heart valves, survive stasis-induced acidemia & substrate depletion, avoid removal by macrophages

Normal Red Blood Cell l l Discoid shape with 7 -8 micron diameter Can squeeze thru 3 micron capillary As it ages, it loses water & surface area, impairing deformability These changes are detected by the RES and trigger removal of the aged RBCs by macrophages

Anemia l l Initial evaluation: MCV If MCV >100: megaloblastic or not? If MCV <80: iron deficient or not? MCV 80 -100: reticulocytosis or not? – – Increased retics: Hemolysis or posthemorrhage Decreased retics: Renal dz, liver dz, hypothyroid, anemia of chronic dz, myelodysplasia, leukemia, myeloma, etc.

Hemolytic Anemia l l Inadequate number of RBCs caused by premature destruction of RBCs Severity depends on rate of destruction and the marrow capacity to increase erythroid production (normal marrow can increase production 5 to 8 fold)

Classification of Hemolytic Anemia l l Site of RBC destruction-Extravascular or Intravascular Cause of destruction- extracorpuscular (abnormal elements in vascular bed that “attack” RBCs) or intracorpuscular (erythrocyte defects- membrane abnormalities, metabolic disturbances, disorders of hemoglobin)

Pathways of RBC Destruction l l Extravascular: RBCs phagocytized by RE cells; RBC membrane broken down; Hemoglobin broken into CO (lung), bilirubin (conjugation and excretion by liver), and iron (binds to transferrin, returns to marrow) Intravascular: Free hemoglobin binds to haptoglobin or hemopexin or is converted to methemalbumin. These proteins are cleared by the liver where the heme is broken down to recover iron & produce bilirubin.

Hemolytic Anemias l Intrinsic RBC causes – – – l Membranopathies: hereditary spherocytosis Enzymopathies: G 6 PD Hemoglobinopathies: Sickle cell disease Extrinsic causes – – Immune mediated: Autoimmune (drug, virus, lymphoid malignance) vs Alloimmune (transfusion reaction) Microangiopathic (TTP) Infection (Malaria) Chemical agents (spider venom)

Diagnosis of Hemolysis l l Symptoms depend on degree of anemia (ie, rate of destruction) Clinical features: anemia, jaundice, reticulocytosis, high MCV & RDW, elevated indirect bili, elevated LDH, low haptoglobin, positive DAT (AIHA) Acute intravascular hemolysis: fever, chills, low back pain, hemoglobinuria Smear: polychromatophilia, spherocytosis & autoagglutination

Acute Intravascular Hemolysis l l l Causes: Blood transfusion, thermal burns, snake bites, infections (clostridia, malaria, Bartonella, Mycoplasma), mechanical heart valves, PNH Hemoglobinemia- pink or red plasma Hemoglobinuria: brown or red after spinning down RBCs Urine hemosiderin: urine hemoglobin reabsorbed by renal tubular cells; detect by staining sediment Low haptoglobin: binds free hemoglobin Methemalbumin: appears after depletion of haptoglobin

Intravascular hemolysis events l l l Acute intravascular hemolysis Immediate drop in Haptoglobin; rises at 2 days; normal at 4 days Hemoglobinemia detectable 6 -12 hrs after event Hemoglobinuria detectable 12 -24 hrs Hemosiderinuria detectable 3 -12 days Methemalbumin detectable 1 -12 days

Acute Extravascular Hemolysis l l Sudden fall in hemoglobin level with no evidence of bleeding or intravascular hemolysis (no hemoglobinemia or hemoglobinuria) Clinical setting usually points to cause

Causes of Extravascular Hemolysis l l l Bacterial & Viral infections Drug- induced Autoimmune Hemoglobinopathies Membrane Structural Defects “Environmental” Disorders- Malignancy associated DIC, TTP, Eclampsia

Infectious causes of hemolysis l l l 5 -20% of pts with falciparum malaria have acute intravascular hemolysis (black water fever); most have mild extravascular hemolysis Clostridial sepsis may cause severe intravascular hemolysis Mild hemolysis occurs with mycoplasma pneumonia; often associated with high titer cold agglutinin; self limited

Drug-induced Hemolysis l l l May occur by an immune mechanism or by challenging the RBC metabolic machinery Oxidant drugs causing hemolysis in G 6 PD deficiency: nitrofurantoin, sulfa drugs, dapsone, primaquine, pyridium, doxorubicin Drugs causing immune-mediated hemolysis: penicillin, quinidine, methyldopa, streptomycin

G 6 PD Deficiency l l l ~10% of African-American males have X-linked A variant The older RBCs are lost from circulation New RBCs have normal or high G 6 PD levels; therefore they can usually compensate for the hemolysis even if the drug is continued

Drug Induced Hemolysis l l Formation of antibodies specific to the drug: in high doses PCN binds RBC membrane, if pt forms Ab against PCN, the RBC are destroyed Induction of Ab to RBC membrane antigens: methyldopa induces autoab to Rh ag Selective binding of streptomycin to RBC membrane with formation of complement fixing antibody All have Coombs (DAT) positive for Ig. G

Autoimmune Hemolytic Anemia l l l Anticipate this cause of hemolysis in infections, collagen vascular diseases, lymphoid malignancies Generally, acute extravascular hemolysis Spherocytes seen; no fragments; elevated LDH; suppressed haptoglobin; reticulocytes Autoantibodies are directed against RBC components (eg, Kell antigen) May be warm-reacting (Ig. G) or cold-reacting (Ig. M) antibody

Autoimmune Hemolytic Anemia l l l Warm reacting abs will show Ig. G +/- C 3 Cold reacting abs will have C 3 only RBCs sensitized to Ig. G only are removed in the spleen; those with complement are destroyed in the liver (Kupffer cells have C 3 b receptors) Warm reacting abs often respond to steroids Cold reacting antibodies are more often resistant to therapy and are associated with lymphoid malignancy

Causes of Autoimmune Hemolysis l l l l SLE Non-Hodgkins lymphomas, CLL Hodgkins Disease Myeloma HIV Hepatitis C Chronic Ulcerative Colitis

Management of Hemolysis l l The increase in RBC production requires adequate iron (intravascular hemolysis) & folate supplies (all hemolytic states) Intravascular hemolysis- transfusion reactionstop transfusion, IVFs to induce diuresis and mannitol (increases renal blood flow & decreases hemoglobin reabsorption)

Management of Extravascular Hemolysis l l l Acute self-limited hemolysis in G 6 PD pts rarely needs Rx; pt education important Severe hemolysis may require transfusion in addition to therapy aimed at specific trigger Iron overload becomes a problem in hemoglobinopathies Parvovirus infection may cause aplastic episodes pts with chronic hemolytic states Pigment gallstones occur in chronic hemolytic states Splenectomy reduces RBC destruction in pts with hereditary spherocytosis

Management of Warm-Ab Autoimmune Hemolysis l l l Steroids block RE clearance of RBCs with Ig. G or C 3 on surface and decrease production of Ig. G antibody Prednisone 1 to 1. 5 mg/kg/day is usual dose Most respond within 2 weeks Very slow taper required Chemotherapy or splenectomy may help if steroids fail Transfusions given if needed, may require “least incompatible” blood; likely will be destroyed at the same rate as the patient’s own blood

Management of Cold-Ab Autoimmune Hemolytic Anemia l l l Usually no treatment required in setting of mycoplasma or EBV infection. Occasionally transfusion is needed. Washed RBCs have less complement and are less likely to trigger further hemolysis. Steroids usually do not help Chemotherapy (eg, cyclophosphamide or chlorambucil) may help In severe cases, plasmapheresis can reduce intravascular antibody titer May have dramatic cold sensitivity; warm infusions, avoid cold exposure
- Slides: 28